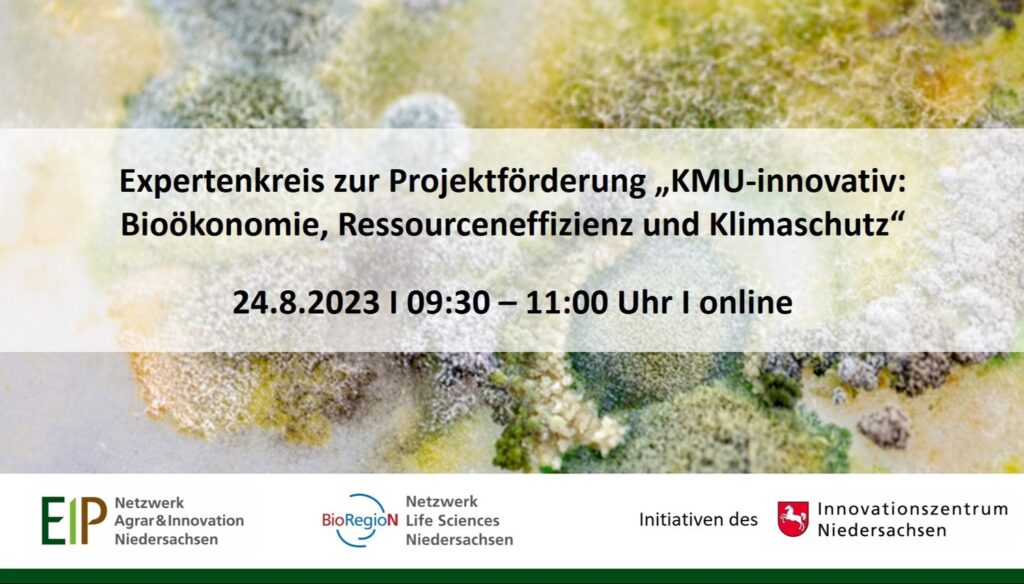

Die BioRegioN, Niedersachsens Technologienetzwerk für Life Sciences, hat sich gemeinsam mit dem Netzwerk EIP Agrar & Innovation Niedersachsen mit ihrer Online-Veranstaltung das Ziel gesetzt einen regen Austausch unter den Teilnehmenden zu fördern und gleichzeitig den Blick auf mögliche Kooperationsvorhaben richten.
Hierzu werden die Projektträger KMUinnovativ: Bioökonomie sowie KMU-innovativ: Ressourceneffizienz und Klimaschutz eingeladen, damit Unternehmer*innen und Forschungseinrichtungen die direkte Möglichkeit haben ihre Fragen und Ideen auszutauschen.
Sie haben eine innovative Idee, die auf eine nachhaltige biobasierte Wirtschaft einzahlt oder sich speziell der Ressourceneffizienz und dem Klimaschutz widmet und suchen Umsetzungspartner*innen oder Fördermöglichkeiten dafür?
Dieser Expert*innenkreis eine Austauschplattform, um mit den Projektträgern hinter den Fördertöpfen, KMUinnovativ: Bioökonomie sowie KMU-innovativ: Ressourceneffizienz und Klimaschutz, und möglichen Umsetzungspartnern in den Austausch zu kommen.
Die Veranstaltung wird am 24. August 2023 von 09:30 – 11:00 Uhr online stattfinden.
Neben einer Erläuterung der Eigenschaften der Fördertöpfe ist ausreichend Zeit für Ihre konkreten Fragen und das Kennenlernen möglicher Partner*innen eingeplant. Zielgruppe dieser Veranstaltungen sind KMU und Forschungseinrichtungen.
Hier geht es zur Anmeldung
PROGRAMM
- Begrüßung & Kurzvorstellungen
- Übersicht „KMU-innovativ“
Petra Kontny, Deutsches Zentrum für Luft- und Raumfahrt e. V. (DLR), Bereich Umwelt und Nachhaltigkeit, Abteilung Klimaschutz- und Umwelttechnik
- Maßnahme „KMU-innovatiov-Bioökonomie“
Dr. Eleonore Glitz, Forschungszentrum Jülich GmbH, Bereich Bioökonomie (BIO) und Technologietransfer (BIO-2)
- Maßnahme „KMU-innovativ: Ressourceneffizienz und Klimaschutz“
Petra Kontny, Deutsches Zentrum für Luft- und Raumfahrt e. V. (DLR), Bereich Umwelt und Nachhaltigkeit, Abteilung Klimaschutz- und Umwelttechnik - Fragerunde und Netzwerken